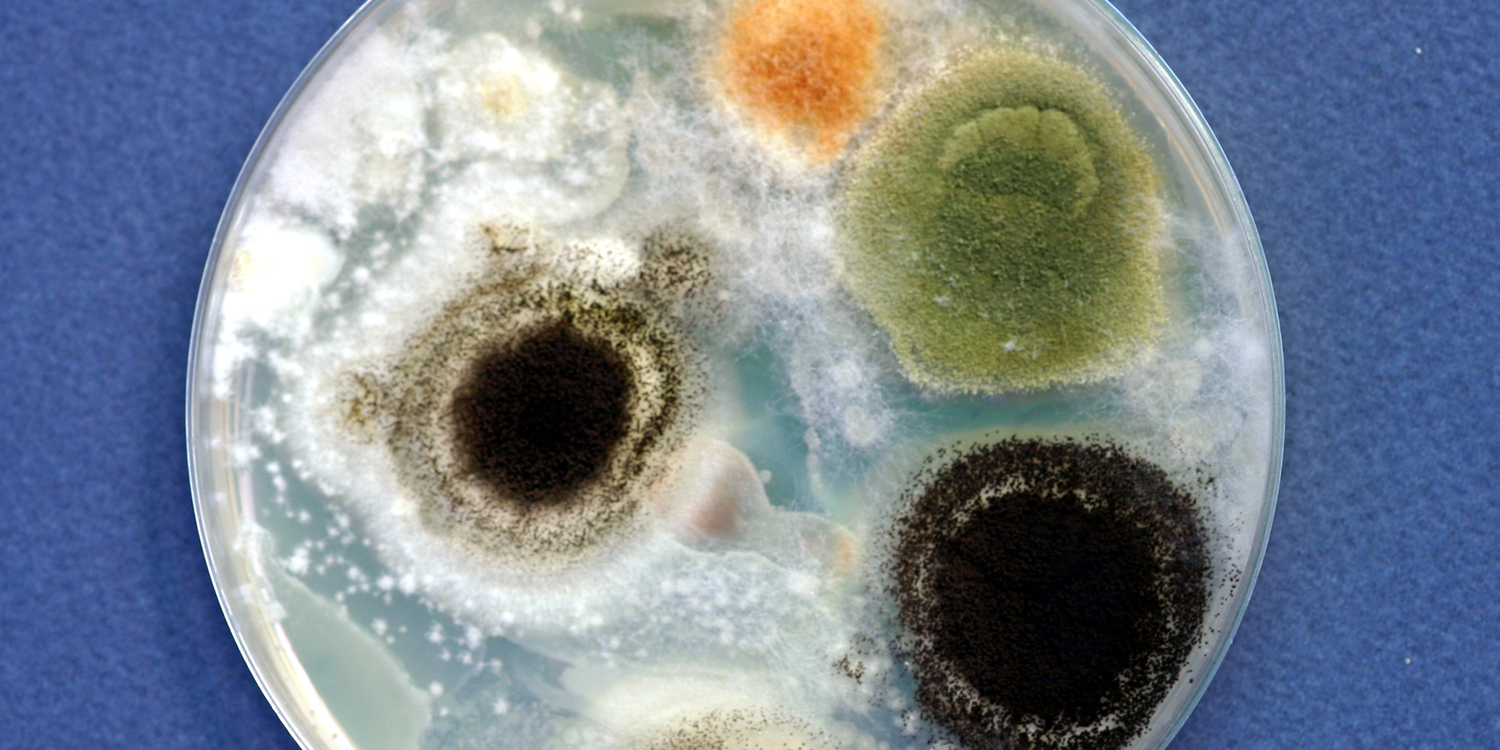
fungus

Could Fungus Be The Real Cause of Mystery Illnesses?
I recently celebrated another birthday, a time of year that always gives me pause to reflect. One thing I’m most grateful for is my incredible inner circle of remarkably knowledgeable, insightful friends. My friend, television host of “Know the Cause” and best-selling author, Doug Kaufmann—whom I regard as a pioneer and a trendsetter—had the best antidote of all for aging: he recently emailed me and told me that he was “too busy to age.” I love that since I think the same way!
Besides such insightful words of wisdom, Doug updated me on his latest news and I want to share some highlights with you—especially if you are looking for root causes of degenerative disease.
“In the past 45 days, I have delivered two Continuing Medical Education presentations. I have stood before hundreds of interested physicians who all seemed to accept and love my belief that links fungus and their mycotoxins to cancer.
Ann Louise, what is happening to me currently is only defined as unbelievable. I feel that I’m 100 percent correct and that my scientific references (which have all been scrutinized by doctors via peer review) prove the facts. So, I believe that antibiotics, booze, and grains impregnated with mycotoxins increase the risk of cancer.
But why?
Because as my presentations prove, FUNGUS mimics and is being misdiagnosed as “cancer.” Know that the Kaufmann Diet halts many skin conditions in time, therefore just diet (the right diet) helps many folks (I worked in a large dermatology clinic in Dallas for five years and saw this hundreds of times), but if supplements are required (to starve the fungus and kill the fungus) it seems that cinnamon, curcumin, and chlorophyll are in a three-way tie for the best natural anti-mycotic fungistatins.
These three all have wonderful health benefits because they stop fungus in its tracks! For acute fungal skin flare ups, in addition to diet, I’d use topical oregano oil or tea tree oil. For chronic fungal dermal conditions like eczema or psoriasis, I’d recommend the “inside out” approach—antifungals like omega 3 and 7 fatty acids, along with beta glucan. I’ve been asked to publish another fungus/cancer article in another respected cancer journal… I’m far too busy to age! lol”
If you think you might be struggling with yeast and candida overgrowth, do consider a natural yeast cleanse. Telltale signs include:
- Incessant cravings for sweets and bread
- Headaches and a lack of mental clarity
- Belly fat that won’t budge
- Gastrointestinal issues
When left untreated, normally harmless Candida albicans can grow out of control throughout your body—all while you may be in the dark about what’s really going on.
Ann Louise Gittleman, Ph.D., C.N.S.
Ann Louise Gittleman, PhD, is a New York Times award-winning author of 30 books on detox, health, and healing, including the international bestselling Fat Flush Plan and Zapped! Visit her blog and join her online Fat Flush Community.
Don't Miss a Thing!
Get the latest articles, recipes, and more, when you sign up for the tasteforlife.com newsletter.

